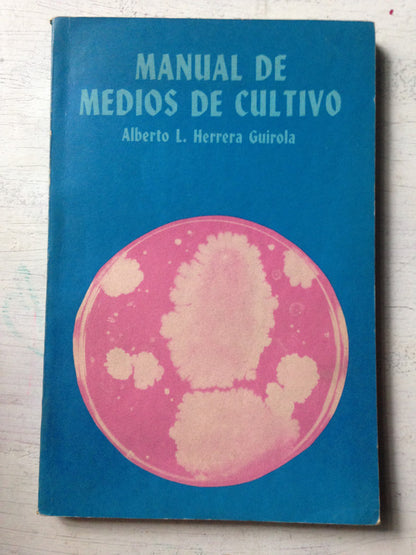
Libro usado en venta: Manual de medios de cultivo de Alberto L. Herrera Guirola; editorial Cientifico Tecnica impreso en 1985 envios a todo el mundo.1

LIBRO USADO
Manual de medios de cultivo – Alberto L. Herrera Guirola – Científico Técnica – 1985 – Blanda
No reviews
1 en existencias
Precio habitual
$ 29.00
Precio habitual
$ 0.00
Precio de oferta
$ 29.00
Precio unitario
/
por
Los gastos de envío se calculan en la pantalla de pago.
No se pudo cargar la disponibilidad de retiro
Título: Manual de medios de cultivo
Autor: Alberto L. Herrera Guirola
Edición: 1985
Editorial: Cientifico Tecnica
Estado del libro: Muy Bueno
Medidas: 15 x 22,7 cm
Colección: Cientifico-Tecnica
Encuadernación: Blanda
Páginas 199
Peso: 220 gramos
Género del libro: Universitarios - Biologia
Idioma del libro: Español
Isbn10: -
Isbn13: -
Compartir en redes




Descripcion del libro:
**Manual de medios de cultivo**: _